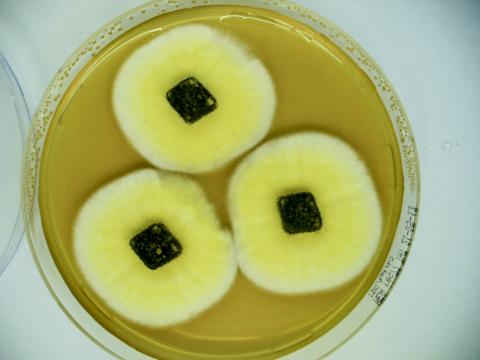

알렉산더 플레밍이 푸른곰팡이에서 페니실린을 발견했듯이, 곰팡이에서 유래한 대규모 추출물 목록에서 신약 찾기에 열중인 연구자들이 있다.
네덜란드 휘브레흐트 인스티투트(Hubrecht Institute)의 예론 덴 헤르토흐(Jeroen den Hertog) 그룹 연구팀은 1만 개 이상의 생물학적 활성 곰팡이 화합물을 연구한 결과를 과학저널 ‘사이언티픽 리포츠’(Scientific Reports) 26일 자에 발표했다.
이들은 베스터딕 인스티투트(Weterdijk Institute) 및 위트레흐트대 연구팀과 협동으로 곰팡이 추출물 라이브러리를 구축해 여기에서 선별한 화합물을 대상으로 연구를 진행해 왔다.
이번 연구에서는 콜레스테롤 저해제인 로바스타틴(lovastatin)을 만드는 새로운 곰팡이 종과 피부암 관련 화합물 등을 발견하는 성과를 거뒀다.
연구팀은 제브라 피쉬의 배아를 이용해 곰팡이 추출물의 생물학적 활성을 테스트했다.
제브라 피쉬를 선택한 것은 이 실험용 물고기가 생리학적으로 인간과 매우 유사한데다 한꺼번에 많은 세포 유형에 대한 효과를 분석할 수 있기 때문이다.
이들은 로바스타틴을 포함해 이미 알려진 다양한 화합물들을 발견한 바 있다. 이런 성과를 바탕으로 연구팀은 곰팡이 추출물 라이브러리가 신약 검색을 위한 충분한 기회를 제공한다고 보고 있다.
로바스타틴 등 다양한 화합물 곰팡이에서 유래
병원에서는 여러 가지 이유로 새로운 치료 화합물을 필요로 한다. 사람들이 나이가 들어감에 따라 생기는 질병과, 기존 치료 약의 내성 등에 대응하기 위해서다.
곰팡이 종인 아스페르길루스 테레우스(Aspergillus terreus)에서 생성된 로바스타틴이 주요 콜레스테롤 저하제로 쓰이는 것과 같이, 곰팡이는 우수하지만 아직 개발되지 않은 화합물의 공급원이다.
휘브레흐트 인스티투트의 옐마 훅스마(Jelmer Hoeksma) 연구원은 “매년 곰팡이에서 생성되는 새로운 화합물이 확인되고 있으나, 지금까지 모든 곰팡이의 아주 작은 부분만 조사했다”고 말하고, “이것은 그만큼 더 많은 생물학적 활성 화합물이 발견될 소지가 있다는 것을 의미한다”고 밝혔다.
1만 개 곰팡이 화합물의 생물학적 활성 조사
전 세계에서 가장 큰 살아있는 곰팡이 컬렉션이 있는 베스터딕 곰팡이 생물다양성 연구소와의 협력을 통해 연구팀은 1만 개 이상의 곰팡이로부터 유래한 대규모 추출물 라이브러리를 만들 수 있었다.
연구팀은 치료 화합물을 찾기 위해 먼저 이 수많은 여과액(filtrates)들이 제브라 피쉬 배아에 미치는 영향을 조사했다.
제브라 피쉬에서는 배아가 발달하는 동안 몸 전체에 미치는 영향을 조사하는 것이 가능하다. 이 실험용 물고기는 인간과 생리학적으로 매우 유사한 동물로서 종종 다양한 질환의 치료 약물을 테스트하는데 사용된다.
제브라 피쉬 배아는 며칠 안에 모든 기관이 발달해 곰팡이 화합물의 생물학적 활성을 쉽게 감지할 수 있다.
아울러 이미 알려진 약물과의 비교를 통해 신약 가능성을 확인할 수 있고, 이 곰팡이 화합물들의 기본적인 작용 메커니즘도 알아낼 수 있다.

색소 통해 피부암 관련 화합물 분리 작업 중
연구팀은 제브라 피쉬 배아에 영향을 미치는 1526개의 생물학적 활성 화합물을 찾아내 그중에서 추가 분석이 필요한 150개의 추출액을 선별해 냈다.
이어 150개 가운데 다시 34개의 이미 알려진 화합물을 분리했다. 이 중에는 레시니시움 푸르푸라세움(Resinicium furfuraceum) 곰팡이 종에서 생성된 콜레스테롤 저해제 로바스타틴도 포함돼 있었다.
앞서 로바스타틴을 추출한 곰팡이 종과는 다른 것으로, 지금까지 이 곰팡이 종이 로바스타틴을 생산한다는 사실은 알려지지 않았었다.
연구팀은 또한 제브라 피쉬 배아의 색소 침착(pigmentation)에 영향을 미치는 추출액들도 발견했다. 다른 연구들에 따르면 색소 침착과 관련된 요인들이 피부암 발병에 중요한 역할을 하는 것으로 알려져 있다.
이에 따라 연구팀은 현재 제브라 피쉬 배아에서 색소 결손을 일으키는 활성 화합물을 곰팡이 추출액으로부터 분리해 내는 작업을 하고 있다.
연구되고 있는 것은 ‘빙산의 일각’
이번 연구는 곰팡이가 생산하는 생물학적 활성 화합물이 여러 분야에 활용 가능한 커다란 다양성을 지니고 있고, 신약을 찾기 위해 이 화합물들을 깊이 연구할 필요가 있다는 점을 강조하고 있다.
훅스마 연구원은 “우리가 구축한 곰팡이 추출물의 대규모 라이브러리는 박테리아에서의 항생제 내성 모델이나 종양 모델과 같은 다른 많은 시스템에서도 테스트할 수 있기 때문에 이번의 연구 보고는 빙산의 일각에 지나지 않는다”고 강조했다.
- 김병희 객원기자
- hanbit7@gmail.com
- 저작권자 2019-11-27 ⓒ ScienceTimes
관련기사

뉴스레터